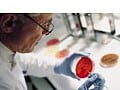
Mokslininkas su laboratoriniais chalatais ir pirštinėmis tiria raudoną Petri lėkštelę, kurioje yra zofenoprilio, o fone sukrautos kelios kitos Petri lėkštelės, išryškinančios pažangius širdies apsaugos tyrimus laboratorijos aplinkoje.

Populiariausios ligos
Rekomenduojamos gydymo įstaigos
Anekdotai
Gydytojas klausia paciento:
- Tai kuo skundžiatės?
- Man kojos juoduoja...
- Plauti bandėte?
- O ką, padeda?- Daugiau anekdotų
Dienos Klausimas
Ruduo nerimo ir įtampos laikotarpis, kas Jums geriausiai padeda ?